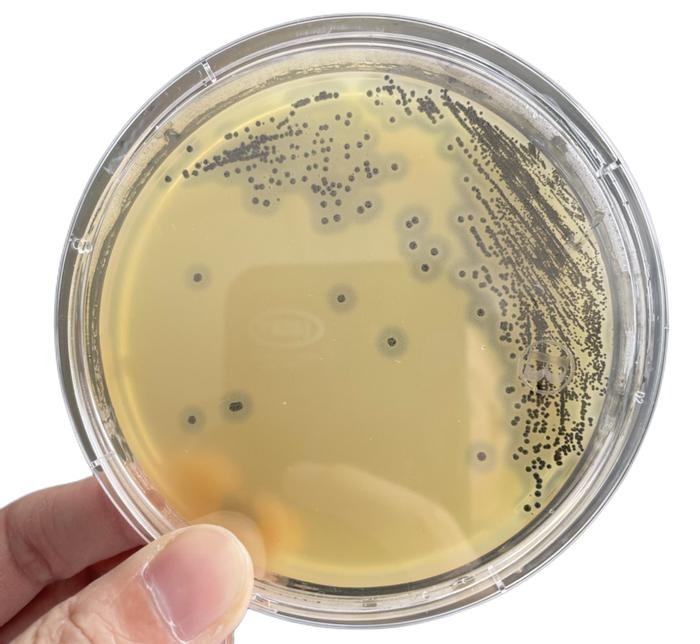
63c8d0adcb3d860cf2ccc71848d1bed8~tplv-be4g95zd3a-image (1).jpeg

成功案例
相关资讯
咨询热线:
18017886821
固话:021-57790908
传真:021-54298177
地址:上海市松江区曹农路5弄40号研磨仪参数没配对,下游数据再好看也白搭
研磨仪买回来了,参数按说明书设的,结果样品研磨完一看,要么没磨透,要么温度明显升高,再要么批次之间重复性差得离谱。折腾半天,问题出在哪还没头绪。
其实大多数情况下,不是仪器的问题,是参数没配对。
为什么同一台机器,别人用得顺你用得愁?
研磨这件事,看起来简单,实际上变量很多。
样品的含水量、纤维结构、细胞壁厚度,都会直接影响研磨效果。同样是植物组织,叶片和根茎需要的研磨条件就完全不同;同样是动物组织,肌肉和脂肪组织的处理方式也不能照搬。
说明书上给的参数,通常是一个通用起点,不是你样品的最优解。
几类常见样品,参数怎么设更合理
植物组织(叶片类)

含水量高、纤维相对细腻,不需要太高的研磨频率。频率过高反而容易造成样品升温,对后续核酸或蛋白提取产生干扰。建议从中低频率起步,分段研磨,中间留有冷却间隔。
植物组织(根茎、种子类)

这类样品硬度大,单纯提高频率往往效果有限,更关键的是研磨珠的选择——珠径太小撞击力不足,太大又可能研磨不均匀。通常需要搭配液氮预冻处理,样品脆化后研磨效率会明显提升。
动物软组织(肝、脾、肾等)

含水量高,容易糊管。建议控制单次研磨时间,不要追求一次研磨到位,多次短时研磨加间歇冷却,既保证效果,也减少蛋白降解风险。
微生物样品
细菌细胞壁较厚,需要较高的研磨强度,但同时对温度极为敏感。低温研磨在这类样品上几乎是标配,冷冻研磨模块的价值在这里体现得最明显。
重复性差,通常是这几个地方出了问题
批次间重复性差,是很多实验室头疼的问题,排查方向一般集中在三块:
样品前处理是否统一——同批样品的取样量、预冻时间、解冻状态是否一致,这些在研磨之前就决定了后续结果的上限。
耗材状态是否稳定——研磨珠反复使用后表面会磨损,撞击效率下降,很多人忽略这一点。建议记录研磨珠的使用次数,定期更换。
仪器本身的运行稳定性——这一点往往到出问题才会被注意到。仪器长期使用后,电机性能、夹具固定状态都可能出现细微变化,定期检查维护能避免很多莫名其妙的批次差异。
高通量处理时,效率和质量怎么兼顾
样本量一大,很多人的第一反应是把参数调猛一点,希望一次搞定。但实际情况是,同一批次里不同位置的样品管,受到的研磨强度本来就存在细微差异,参数越极端,这种差异就越容易被放大。
更稳妥的做法是在方法开发阶段多花些时间,找到一个在效率和均一性之间平衡的参数组合,后续批量处理才真正省心。
在高通量研磨这个方向上,净信积累了比较丰富的方法数据,不同样品类型对应的参数范围有据可查,新用户可以以此为参考起点,减少自己摸索的时间成本。
一个值得养成的习惯
每次调整参数,哪怕只是小幅改动,都记录下来,连同研磨结果一起存档。
这件事前期看起来麻烦,但做到一定积累之后,你会发现自己建立了一套针对本实验室样品类型的专属参数库——出了问题有据可查,换人操作也不用重新摸索。
研磨这个步骤在整个实验流程里往往不起眼,但它的稳定性直接影响下游结果的可靠性。把这一步做扎实,值得。
- 研磨仪参数没配对,下游数据再好看也白搭 2026-04-22
- 冷冻研磨仪高效解决低温样品前处理中样品活性被破坏难题 2026-03-23
- 全自动样品快速研磨仪优势是什么? 2026-03-19
- 净信真空离心浓缩仪原理 核心技术打造高效样品浓缩解决方案 2026-03-18
- 上海净信PLUS版超高通量组织研磨仪|解锁大通量样品前处理新··· 2026-03-17
- 全自动浸入式液氮冷冻研磨仪怎么选?上海净信这款解锁高效研磨新··· 2026-03-16
- 上海净信的真空冷冻研磨仪JXCL-ZK更适合研磨胶原蛋白? 2026-03-13
- 上海净信样品前处理一体机JXYQ-5实验室多功能样本处理设备 2026-02-26
- 丙午新岁 马力全开 | 上海净信2026春节放假通知 2026-02-10
- 高速冷冻研磨均质仪能研磨软糖吗?实操实验告诉你答案 2026-02-05


沪公网安备31011702889602号